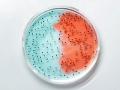
Researchers reveal how good friendships are associated with healthier gut microbiome - Hindi News | Researchers reveal how good friendships are associated with healthier gut microbiome | Latest health News at Lokmattimes.com

Department Of Psychiatry Of The University Of OxfordFOLLOW
Department of psychiatry of the university of oxford, Latest News
![Study finds new tool to study complex genome interactions - Hindi News | Study finds new tool to study complex genome interactions | Latest technology News at Lokmattimes.com Study finds new tool to study complex genome interactions - Hindi News | Study finds new tool to study complex genome interactions | Latest technology News at Lokmattimes.com]()
Washington [US], June 20 : Researchers uncovered previously unknown information about the genome's spatial architecture by relying solely on ... ...
![Breastfeeding children for longer period leads to better results in their school: Study - Hindi News | Breastfeeding children for longer period leads to better results in their school: Study | Latest technology News at Lokmattimes.com Breastfeeding children for longer period leads to better results in their school: Study - Hindi News | Breastfeeding children for longer period leads to better results in their school: Study | Latest technology News at Lokmattimes.com]()
Washington [US], June 6 : Researchers found children who have been breastfed for a longer period of time appear ... ...
![Study: Virtual consultation may significantly reduce carbon footprint of healthcare - Hindi News | Study: Virtual consultation may significantly reduce carbon footprint of healthcare | Latest technology News at Lokmattimes.com Study: Virtual consultation may significantly reduce carbon footprint of healthcare - Hindi News | Study: Virtual consultation may significantly reduce carbon footprint of healthcare | Latest technology News at Lokmattimes.com]()
Washington [US], May 6 : Virtual consultation, according to recent research published in the Journal of Medical Internet Research, ... ...
![Virtual consulting may significantly reduce carbon footprint in health care: Study - Hindi News | Virtual consulting may significantly reduce carbon footprint in health care: Study | Latest technology News at Lokmattimes.com Virtual consulting may significantly reduce carbon footprint in health care: Study - Hindi News | Virtual consulting may significantly reduce carbon footprint in health care: Study | Latest technology News at Lokmattimes.com]()
Washington [US], May 3 : According to new research published in the Journal of Medical Internet Research, virtual consultation ... ...
![Researchers reveal how good friendships are associated with healthier gut microbiome - Hindi News | Researchers reveal how good friendships are associated with healthier gut microbiome | Latest health News at Lokmattimes.com Researchers reveal how good friendships are associated with healthier gut microbiome - Hindi News | Researchers reveal how good friendships are associated with healthier gut microbiome | Latest health News at Lokmattimes.com]()
Even though social ties are essential for the health and well-being of social animals like humans and other primates, ... ...
![Study suggests having good friendships might be linked to healthier gut microbiome - Hindi News | Study suggests having good friendships might be linked to healthier gut microbiome | Latest health News at Lokmattimes.com Study suggests having good friendships might be linked to healthier gut microbiome - Hindi News | Study suggests having good friendships might be linked to healthier gut microbiome | Latest health News at Lokmattimes.com]()
Despite the fact that social relationships are crucial for the health and well-being of social animals like humans and ... ...
![A good friendship a day keeps gut-diseases away: Study - Hindi News | A good friendship a day keeps gut-diseases away: Study | Latest health News at Lokmattimes.com A good friendship a day keeps gut-diseases away: Study - Hindi News | A good friendship a day keeps gut-diseases away: Study | Latest health News at Lokmattimes.com]()
Man, like other primates, is a social animal. Wholesome social connections help man remain in the pink of health, ... ...